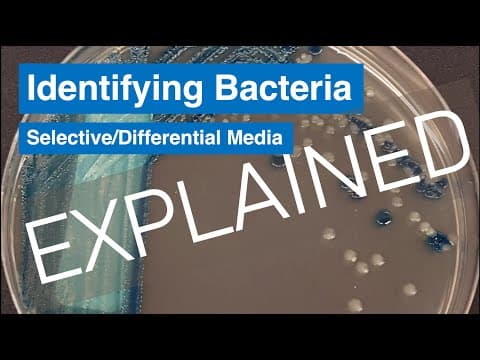
Bacterial Culture: Microbiology and Aseptic Technique Lab

Biology Experiments for Kids
Learn about living organisms and life processes

Ant Farm Observation: Insect Social Behavior Science for Young Kids
Teaches insect social behavior and ecosystems. Living science observation project.

Yeast Fermentation Balloon: Microorganism Respiration Science
Teaches microbiology and fermentation. Shows living organisms consuming food and producing gas.

Bird Beak Adaptation: Natural Selection Science Game for Students
Demonstrates adaptation and natural selection. Shows how body structures match functions.

Mold Growth Experiment: Fungi and Environmental Factors Study
Teaches fungi biology and environmental factors. Shows optimal conditions for microorganism growth.

Fingerprint Analysis: Genetics and Heredity Science for Students
Teaches genetic traits and individual uniqueness. Forensic science introduction.

Plant vs Animal Cell Study: Microscope Biology Lab for Middle School
Teaches cell structure and organization. Introduces microscope skills and cell differentiation.

Punnett Square Genetics: Probability and Heredity Experiment
Teaches Mendelian genetics and probability. Verifies theoretical genetic ratios experimentally.

Drosophila Genetics: Fruit Fly Heredity and Gene Linkage Study
Advanced classical genetics using model organism. Demonstrates gene linkage and recombination.

Growing Bean Sprouts: Plant Life Cycle Observation for Preschoolers
Teaches plant growth and life cycles. Develops observation and recording skills.

Leaf Rubbing Art: Plant Diversity and Structure for Kids
Introduces plant diversity and structure. Combines art with nature observation.

Butterfly Life Cycle: Complete Metamorphosis Science for Preschool
Teaches complete metamorphosis and life cycles. Full transformation in real time.

Celery Color Change: Plant Vascular System and Capillary Action
Demonstrates plant vascular systems and capillary action. Makes invisible water transport visible.

Transpiration Rate Measurement: Plant Water Loss Potometer Lab
Quantifies plant water metabolism. Shows environmental factors affecting transpiration.

Cellular Respiration Rate: Yeast Metabolism and Q10 Temperature Coefficient
Quantifies cellular respiration and enzyme kinetics. Demonstrates temperature's effect on biochemical reactions.

Hardy-Weinberg Equilibrium: Population Genetics Simulation Lab
Teaches population genetics and evolution. Demonstrates genetic equilibrium conditions.

Five Senses Exploration: Human Body Science Activities for Toddlers
Introduces human sensory systems. Develops awareness of how we perceive the world.

Heart Rate Exercise Lab: Cardiovascular System Science for Kids
Teaches cardiovascular system and exercise effects. Introduces data collection and graphing.

Earthworm Habitat: Decomposer Science and Soil Biology for Kids
Teaches decomposers' role in ecosystems. Shows how worms improve soil health.

DNA Extraction from Strawberries: Genetics Lab for Elementary Students
Teaches genetics and cell structure. Makes invisible DNA visible to naked eye.

Owl Pellet Dissection: Food Chain and Predator Biology Lab
Teaches food chains and carnivore digestion. Real-world forensic biology investigation.

Photosynthesis Oxygen Production: Plant Biology Experiment
Demonstrates photosynthesis and gas exchange. Makes oxygen production visible.

Enzyme Activity Lab: Catalase and Hydrogen Peroxide Reaction
Teaches enzyme catalysis and factors affecting enzyme activity. Shows biological catalysts in action.

Frog Dissection Lab: Vertebrate Anatomy and Organ Systems
Teaches vertebrate anatomy and organ systems. Hands-on comparative anatomy study.

Bacterial Culture: Microbiology and Aseptic Technique Lab
Demonstrates microorganisms everywhere and sterile technique importance. Microbiology fundamentals.
DNA Gel Electrophoresis: Molecular Biology Lab Technique
Core molecular biology technique for DNA analysis. Used in forensics, genetics research, medical diagnostics.
About Biology for Young Learners
Biology is a fascinating field of science that helps children understand the world around them. Our biology experiments are designed to be safe, educational, and fun for kids of all ages. Each experiment includes step-by-step instructions, video demonstrations, and explanations of the science behind it.